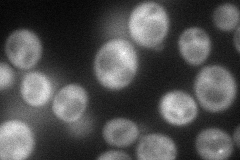
YDR206W
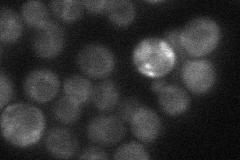
YDR206W
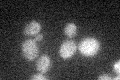
YDR206W

View description
Protein involved in inhibition of translation and nonsense-mediated decay; interacts with cap binding protein Cdc33p and with Nam7p; localizes to P-bodies upon glucose starvation; mRNA abundance regulated by mRNA decay factors
Localization:
Intensity:
Fold change:
Significance:
-
C’ GFP library in SD

below threshold17.19 -
N' NOP1pr-GFP in SD
cytosol78.5919 -
N' TEF2pr-mCherry in SD

cytosol61.1545 -
N' NATIVEpr-GFP in SD
cytosol27.2778 -
N' TEF2pr-VC and Cyto-VN in SD

cytosol36.421 -
C’ GFP library in SD+DTT

cytosol16.330.95No -
C’ GFP library in SD+H2O2
cytosol15.930.92No -
C’ GFP library in Starvation Media

cytosol14.080.81No -
C’ GFP library on the background of Pup2-DaMP

below threshold -
C’ GFP library on the background of CCT mutant

below threshold17.70491.02975No
